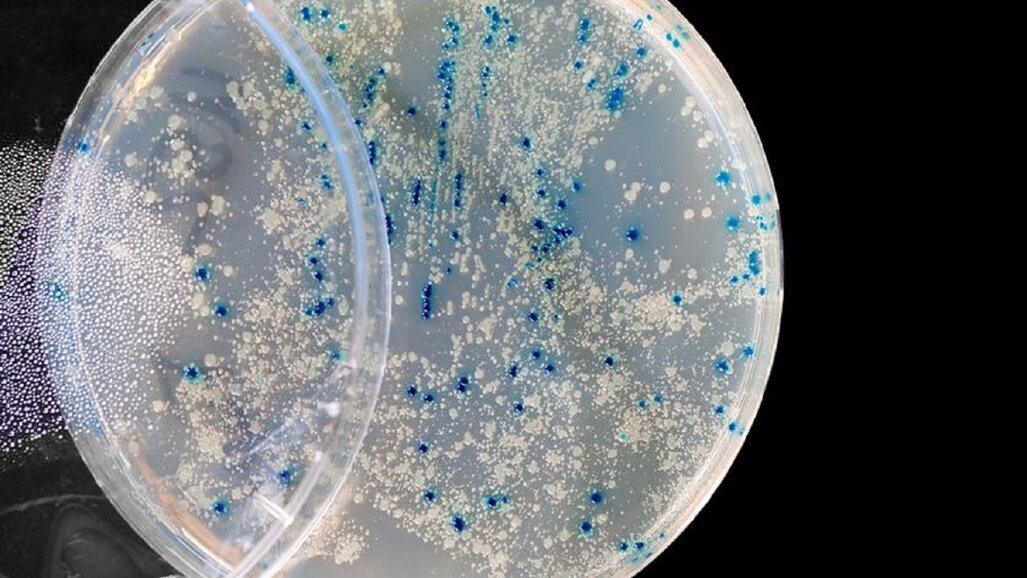
Wirusy mogą „podsłuchiwać” organizm gospodarza

Wirusy mogą wykorzystywać informacje zebrane ze środowiska, aby zdecydować, czy „siedzieć cicho” w swoim gospodarzu, czy zacząć się namnażać – wynika z badań przeprowadzonych przez mikrobiologów z University of Maryland, Baltimore County (UMBC). Zdaniem badaczy, odkrycie będzie miało w przyszłości wpływ na rozwój leków przeciwwirusowych.
Badanie ekspertów z amerykańskiego University of Maryland, Baltimore County (UMBC) skupiło się na bakteriofagach, czyli wirusach, które atakują bakterie. „Zdolność wirusa do wychwytywania informacji ze swojego środowiska dodaje kolejną warstwę złożoności do interakcji wirus-gospodarz” – mówił Ivan Erill, prof. nauk biologicznych i główny autor pracy opublikowanej na łamach Frontiers in Microbiology. Jak dodał, w tej chwili wirusy wykorzystują tę zdolność na swoją korzyść. Ale jak przyznał, w przyszłości będzie można wykorzystać to przeciwko nim.
W badaniu fagi, bo tak w skrócie nazywa się bakteriofagi, infekowały swoich gospodarzy tylko wtedy, kiedy komórki bakterii miały specjalne wyrostki, pomagające im poruszać się i kopulować. Bakterie te wytwarzały białko o nazwie CtrA, które kontroluje, kiedy wytwarzają się te wyrostki (a dokładniej wici i pilusy).
Odkrycie pokazuje, że wiele fagów zależnych od wyrostków ma w swoim DNA wzory, do których białko CtrA może się przyczepić. Te regiony zwane są miejscami wiążącymi. „Fag posiadający miejsce wiążące dla białka produkowanego przez gospodarza jest niezwykły” – mówił Erill. Dzięki szczegółowej analizie genomowej odkryto, że miejsca wiążące nie były unikalne dla pojedynczego faga, czy nawet pojedynczej grupy fagów. Wiele różnych typów fagów miało miejsca wiążące CtrA, ale wszystkie one wymagały od swoich gospodarzy posiadania wici i/lub pilusów, aby je zainfekować. Eksperci uznali, że to nie może być przypadek.
„Zdolność do monitorowania poziomu białek CtrA była wymyślana wielokrotnie w toku ewolucji przez różne fagi infekujące różne bakterie” – tłumaczył Erill. Zauważył, że kiedy odległe gatunki wykazują podobną cechę, nazywa się to ewolucją konwergentną. Tu naukowiec widzi podobieństwo pomiędzy fagami a bakteriami. „Wszystko, co wiemy o fagach, każda strategia ewolucyjna, którą opracowały, przekłada się na wirusy, które infekują rośliny i zwierzęta” – podkreślił ekspert. „Jest to prawie pewne, więc jeśli fagi podsłuchują swoich gospodarzy, co wynika z badań, wirusy, które atakują ludzi z pewnością robią to samo” – dodał.
Kluczowym wnioskiem tych badań jest to, że wirus wykorzystuje „wywiad komórkowy” do podejmowania decyzji. „A jeśli dzieje się to u bakterii, to prawie na pewno dzieje się to u roślin i zwierząt, ponieważ jest to strategia ewolucyjna” - mówił prof. nauk biologicznych. „Na przykład, aby zoptymalizować swoją strategię przeżycia i replikacji (powielania), wirus zwierzęcy może chcieć wiedzieć, w jakim rodzaju tkanki się znajduje lub jak silna jest odpowiedź immunologiczna gospodarza na infekcję. Chociaż myślenie o wszystkich informacjach, które wirusy mogą zebrać i wykorzystać do wywołania choroby, może być niepokojące, odkrycia te otwierają również możliwości dla nowych terapii” – dodał główny autor badań. „Jeśli opracowujesz lek przeciwwirusowy i wiesz, że wirus nasłuchuje określonego sygnału, to może uda ci się go oszukać” – podkreślił.
źródło: EurekAlert.org
ĆENNAJ, Indie: Cyfrowe procesy projektowania i wytwarzania oraz technologie oparte na czujnikach znajdują coraz szersze zastosowanie w terapii z ...
Zdaniem Yanna Maidmenta – dentysty z Edynburga, coraz więcej pacjentów cierpi na mimowolne zaciskanie zębów w wyniku stresu ...
Dr John Viviano, lekarz dentysta i dyplomowany specjalista Amerykańskiej Rady Stomatologicznej Medycyny Snu (ang. American Board of Dental Sleep Medicine ...
FILADELFIA, USA: Niedawno opublikowany artykuł przypomina, że personel medyczny, w tym lekarze dentyści mogą mieć kluczową rolę w identyfikowaniu i ...
Mało kto zwraca uwagę na dodatkowe certyfikaty gwarantujące wyższą jakość i bezpieczeństwo odzieży, nawet jeśli po jej założeniu wystąpi ...
Tzw. zęby mądrości rosną późno, czasem przez wiele lat, często nie nadają się do gryzienia, a nawet te schowane w dziąśle mogą ...
Oporność na antybiotyki staje się coraz ważniejszym problemem w stomatologii, medycynie i zdrowiu publicznym. Ponieważ nadmierne przepisywanie ...
Lęk stomatologiczny jest uważany na całym świecie za problem zdrowia publicznego ze względu na jego wpływ na zdrowie jamy ustnej i jakość życia ...
Kalifornijscy naukowcy pracują nad małym, ale potężnym sojusznikiem, który może pomóc w zapobieganiu infekcjom po leczeniu kanałowym. W badaniu ...
Naukowcy od dawna wiedzą, że nadużywanie antybiotyków może wyrządzić więcej szkody niż pożytku, co wynika np. z oporności na nie. Jednak badania ...
Webinarium na żywo
czw. 25 czerwca 2026
8:00 (CET) Warsaw
Dr. Hatem Algraffee, Cat Edney
Webinarium na żywo
wto. 30 czerwca 2026
5:00 (CET) Warsaw
Webinarium na żywo
wto. 30 czerwca 2026
7:30 (CET) Warsaw
Prof. Dr. Anahita Jablonski-Momeni
Webinarium na żywo
śro. 1 lipca 2026
2:00 (CET) Warsaw
Linda Hecker MS, BSDH, RDH
Webinarium na żywo
śro. 1 lipca 2026
2:00 (CET) Warsaw
Webinarium na żywo
czw. 2 lipca 2026
5:00 (CET) Warsaw
Dr. Albéric Santamaria-Loisy
Webinarium na żywo
czw. 2 lipca 2026
8:00 (CET) Warsaw



 Austria / Österreich
Austria / Österreich
 Bośnia i Hercegowina / Босна и Херцеговина
Bośnia i Hercegowina / Босна и Херцеговина
 Bułgaria / България
Bułgaria / България
 Chorwacja / Hrvatska
Chorwacja / Hrvatska
 Czechy i Słowacja / Česká republika & Slovensko
Czechy i Słowacja / Česká republika & Slovensko
 Francja / France
Francja / France
 Niemcy / Deutschland
Niemcy / Deutschland
 Grecja / ΕΛΛΑΔΑ
Grecja / ΕΛΛΑΔΑ
 Węgry / Hungary
Węgry / Hungary
 Włochy / Italia
Włochy / Italia
 Holandia / Nederland
Holandia / Nederland
 nordycki / Nordic
nordycki / Nordic
 Polska / Polska
Polska / Polska
 Portugalia / Portugal
Portugalia / Portugal
 Rumunia i Mołdawia / România & Moldova
Rumunia i Mołdawia / România & Moldova
 Słowenia / Slovenija
Słowenia / Slovenija
 Serbia i Czarnogóra / Србија и Црна Гора
Serbia i Czarnogóra / Србија и Црна Гора
 Hiszpania / España
Hiszpania / España
 Szwajcaria / Schweiz
Szwajcaria / Schweiz
 indyk / Türkiye
indyk / Türkiye
 Wielka Brytania i Irlandia / UK & Ireland
Wielka Brytania i Irlandia / UK & Ireland
 Międzynarodowy / International
Międzynarodowy / International
 Brazylia / Brasil
Brazylia / Brasil
 Kanada / Canada
Kanada / Canada
 Ameryka Łacińska / Latinoamérica
Ameryka Łacińska / Latinoamérica
 USA / USA
USA / USA
 Chiny / 中国
Chiny / 中国
 Indie / भारत गणराज्य
Indie / भारत गणराज्य
 Pakistan / Pākistān
Pakistan / Pākistān
 Wietnam / Việt Nam
Wietnam / Việt Nam
 ASEAN / ASEAN
ASEAN / ASEAN
 Izrael / מְדִינַת יִשְׂרָאֵל
Izrael / מְדִינַת יִשְׂרָאֵל
 Algieria, Maroko i Tunezja / الجزائر والمغرب وتونس
Algieria, Maroko i Tunezja / الجزائر والمغرب وتونس
 Bliski Wschód / Middle East
Bliski Wschód / Middle East

To post a reply please login or register